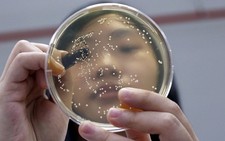

Đại học Nghiên cứu Hạt nhân Quốc gia Nga (MEPhI)
Quá trình phân tích bất kỳ vật liệu nào đều liên quan đến việc xác định thành phần nguyên tố của nó - nghĩa là, biết được khối lượng các nguyên tố của bảng tuần hoàn trong mẫu đó.
Các phương pháp truyền thống đòi hỏi phải chuẩn bị rất lâu để phân tích các mẫu. Ngoài ra, các nhà khoa học phải so sánh mẫu được phân tích với mẫu vật chất được gọi là tiêu chuẩn, mà việc sử dụng mẫu tiêu chuẩn làm tăng chi phí phân tích. Đây là những mẫu đắt tiền, thành phần của chúng được biết rõ (ví dụ: hợp kim đồng với một số tạp chất nhất định).
Các nhà khoa học từ trường Đại học Nghiên cứu Hạt nhân Quốc gia Nga (MEPhI) đề xuất một công nghệ mới - chương trình hoạt động của thiết bị (máy phân tích khối phổ) để phân tích trực tiếp thành phần nguyên tố của các mẫu vật liệu, mà không cần dùng mẫu tiêu chuẩn. Kết quả nghiên cứu được công bố trên tạp chí European Journal of Mass Spectrometry.
Công nghệ này có thể được áp dụng trong nhiều lĩnh vực khác nhau - từ pháp y (trong ngành này tốc độ xác định thành phần là đặc biệt quan trọng) đến y học (đặc biệt trong việc phân tích các nguyên tố vi lượng trong thành phần sợi tóc và móng tay). Ngoài ra, phương pháp này có thể cải thiện tính chính xác trong việc xác định thành phần các đối tượng di chuyển qua biên giới tại các nhà ga và sân bay, hoặc để tăng tốc độ xác định điều kiện môi trường (tối ưu hóa quá trình phân tích, ví dụ, các mẫu đất).
"Công việc của chúng tôi có tầm quan trọng thực tiễn rõ ràng nhất trong những dự án tiềm năng, vì trên cơ sở này có thể tạo ra thiết bị rất nhỏ gọn để xác định thành phần vật liệu mà không dùng mẫu tiêu chuẩn, và thiết bị này sẽ có độ nhạy cảm cao, hiệu suất cao và do đó có sức cạnh tranh lớn hơn" - Giáo sư MEPhI Alexey Sysoev cho biết.
Công nghệ được gọi là "phân tích thành phần vật liệu mà không dùng mẫu tiêu chuẩn" – xác định trực tiếp thành phần nguyên tố, mà không đòi hỏi phải thực hiện cuộc phân tích song song với các mẫu tiêu chuẩn mà thành phần của chúng đã được biết đến.
Phương pháp này liên quan đến việc cải tiến máy phân tích khối phổ bằng laser. Theo các nhà khoa học MEPhI, ưu điểm của thiết bị phân tích mới là khả năng sử dụng các dạng năng lượng khác nhau, kích thước nhỏ gọn, và yêu cầu tối thiểu đối với các nguồn năng lượng. Trong số các ưu điểm khác, các nhà khoa học ghi nhận khả năng phân tích tất cả các lớp chất, độ tinh khiết của phương pháp, khả năng phân tích cục bộ và từng lớp. Cũng cần lưu ý rằng, phương pháp này làm giảm đáng kể chi phí một thiết bị và mỗi lần phân tích.

Bình luận hay